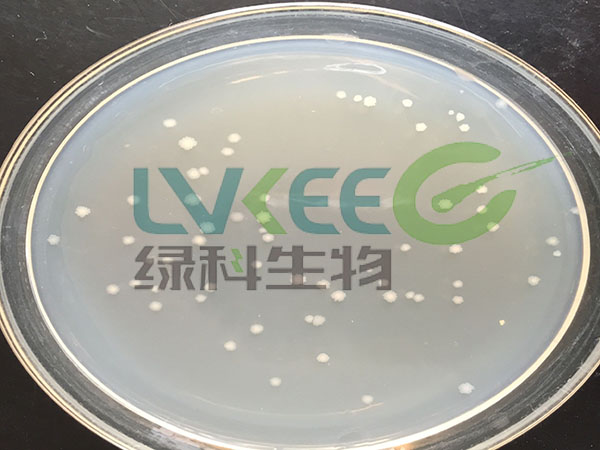
枯草芽孢杆菌菌落图

枯草芽孢杆菌很多人都熟知,但是他的具体功效你了解多少呢?下面就从种植、水产、养殖、环保四个方面讲一下我们绿科的热销产品之一枯草芽孢杆菌的应用。
1.枯草芽孢杆菌在种植中应用
俗称“生物农药”。平衡土壤pH值,有益微生物调节植物根系生态环境,防止土传病虫害,解除化肥、农药及有害因子对土壤的破坏,提高作物抗病、抗寒,抗旱、防热、防病防虫能力,改善产品品质。促进根系生长及作物生长、成熟、降低成本、增加产量、提高收入。
2.枯草芽孢杆菌在养殖中应用
促进肠道有益厌氧菌生长,降低大肠杆菌、弧菌、杆状病菌数量,增强抗应激能力,有效防止腹泻(痢疾)、便秘,减少疾病发生。促进生长,调节免疫力,优化养殖环境等功效。
3.枯草芽孢杆菌在改善水质方面的应用
能大量消耗水体中的有机质,将其分解为小分子有机酸、氨基酸及氨,改善水质,为单胞藻提供营养。抑制有害藻类及病原微生物繁殖,增加水体活力,净化养殖环境。
4.枯草芽孢杆菌在环保中的应用
降解有机物质,抑制腐败细菌的生长,将难降解的有机物分解为小分子物质,进一步降解为二氧化碳和水,不产生二次污染,改善污水水质,是环境友好型高效微生物菌剂。
枯草芽孢杆菌是从自然界中筛选出来的微生物,经独特的发酵工艺生产而成。使用安全,无毒,无腐蚀,对人畜动物无害,具有生态安全性。绝对是人们的好帮手。